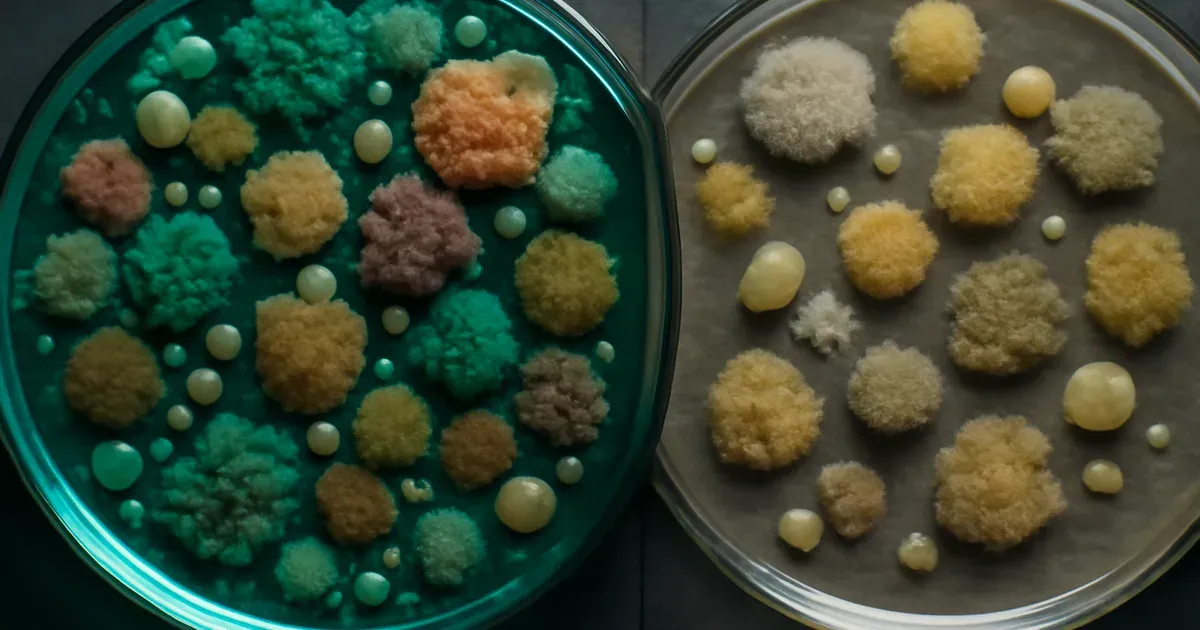
Illustration of diverse versus low-diversity gut microbiome linked to estrogen decline in perimenopause

Perimenopause & Gut Health: Your Top Questions Answered
Discover how perimenopause disrupts gut health, the microbiome, and the gut-brain axis — plus evidence-based answers to your top digestive questions.

If your digestion has felt unpredictable lately — more bloating, new food sensitivities, or stubborn constipation — you are not imagining it. For many women in their 40s, these changes are directly tied to the hormonal shifts of perimenopause. The connection between perimenopause and gut health is real, well-researched, and still widely misunderstood. This article answers the questions women are actually searching for, with evidence-based clarity.

Quick Navigation
What does perimenopause do to your gut?
How do hormones affect the gut microbiome?
What is the gut-brain axis and why does it matter in perimenopause?
Why am I suddenly bloated and constipated in my 40s?
Can improving gut health ease perimenopause symptoms?
What foods support the microbiome during perimenopause?
Soluble vs. Insoluble Fibre: Which is better during perimenopause?
When should I see a doctor about digestive changes in perimenopause?
What does perimenopause do to your gut?
Perimenopause triggers measurable changes in gut function through declining levels of estrogen and progesterone — two hormones that actively regulate the digestive tract. These changes can affect how quickly food moves through your intestines, how well your gut lining holds together, and which bacteria thrive in your microbiome.
The result is a cluster of symptoms that can feel confusing because they seem unrelated to reproductive health. Bloating, constipation, incomplete emptying, and new food sensitivities are all recognised features of perimenopause and gut health disruption.
This is not a coincidence. Estrogen receptors are found throughout the gastrointestinal tract, meaning the gut is directly responsive to hormonal fluctuation. Understanding this connection is the first step toward targeted, effective relief.
How do hormones affect the gut microbiome?
Estrogen plays an active role in maintaining the diversity and balance of the gut microbiome — the vast community of trillions of bacteria that live in your intestines. When estrogen levels decline during perimenopause, this microbial ecosystem can shift in ways that affect digestion, immunity, and even mood.
Research shows that lower estrogen is associated with reduced microbial diversity, which mirrors patterns more commonly seen in male gut profiles (Bharwani et al., 2020). Lower diversity is linked to:
- Increased bloating and gas
- Slower transit time and constipation
- Reduced absorption of key nutrients
- Greater intestinal inflammation
The gut microbiome also metabolises estrogen itself, through a collection of bacteria sometimes called the "estrobolome." When microbial diversity drops, this recycling process becomes less efficient, which can further amplify hormonal imbalance. The relationship between hormones and the microbiome is genuinely two-directional.
What is the gut-brain axis and why does it matter in perimenopause?
The gut-brain axis is the two-way communication network linking your digestive system to your central nervous system, and it becomes particularly sensitive during perimenopause. Hormonal fluctuations affect this signalling pathway directly, which is why digestive symptoms so often coincide with mood changes, sleep disruption, and brain fog.
Estrogen and progesterone influence neurotransmitters like serotonin — approximately 90% of which is produced in the gut. When hormone levels shift, serotonin production and gut motility can both be affected simultaneously.
Sleep disturbances, which affect up to 60% of perimenopausal women, further disrupt gut-brain communication by altering appetite hormones and slowing intestinal movement. Stress, another common feature of this life stage, can trigger bloating, urgency, or cramping through the same axis. Supporting the gut-brain connection — through sleep hygiene, stress management, and consistent eating patterns — is as important as dietary changes alone.
Why am I suddenly bloated and constipated in my 40s?
Sudden bloating and constipation in your 40s are frequently linked to the hormonal changes of perimenopause, even when your diet has not changed. Declining progesterone slows gut motility — the muscular contractions that move food through your intestines — leading to a backed-up, uncomfortable feeling.
At the same time, a weakening gut barrier (sometimes called "leaky gut") can allow particles to cross into the bloodstream, triggering low-grade inflammation and sensitivity to foods that previously caused no issues. This helps explain why perimenopause and gut health problems often arrive together.
Other contributing factors include:
- Disrupted sleep altering bowel rhythm and appetite signals
- Heightened stress response slowing or speeding digestion unpredictably
- Changes in eating patterns — skipped meals, late-night snacking, reduced fibre — driven by fatigue or mood shifts
If these symptoms appeared alongside irregular periods, night sweats, or mood changes, the gut is likely responding to hormonal change rather than an isolated digestive issue.
Can improving gut health ease perimenopause symptoms?
Actively supporting gut health during perimenopause can reduce the severity of digestive symptoms and may positively influence hormonal balance. Because the gut microbiome participates in estrogen metabolism, a healthier, more diverse microbiome may help the body recycle and regulate estrogen more effectively.
Beyond hormones, a well-functioning gut supports:
- More stable mood and energy through serotonin production
- Better sleep quality via the gut-brain axis
- Reduced systemic inflammation, which worsens many perimenopause symptoms
- Improved absorption of key nutrients including magnesium, B vitamins, and calcium
Practical strategies with solid evidence include eating meals at consistent times, prioritising 7–8 hours of sleep, incorporating daily movement, and gradually increasing dietary fibre from diverse plant sources. These are not complicated interventions — but consistency matters far more than perfection.
What foods support the microbiome during perimenopause?
Feeding a diverse gut microbiome during perimenopause starts with eating a wide variety of plant-based foods across many colours and textures. Each plant food contains different types of fibre and polyphenols that feed distinct bacterial species, helping to maintain the diversity that estrogen decline tends to reduce.
Key food strategies include:
- Fermented foods — yogurt, kefir, sauerkraut, kimchi — introduce beneficial bacteria directly and have been shown to increase microbiome diversity
- Colourful vegetables and legumes — provide prebiotic fibre and antioxidants that feed beneficial strains
- Oats and chia seeds — rich in soluble fibre, which supports motility and feeds microbiome without worsening bloating
- Limiting ultra-processed foods and added sugars, which reduce microbial diversity and promote inflammatory bacterial strains
One important caution: prebiotic additives found in packaged foods — such as inulin, chicory root, or FOS (fructooligosaccharides) — can worsen bloating and gas in women with already-sensitive guts. Whole food sources of fibre are a safer and more effective starting point.

Soluble vs. Insoluble Fibre: Which is better during perimenopause?
Not all fibre behaves the same way in a perimenopausal gut, and choosing the right type can make a significant difference to symptoms. Soluble fibre dissolves in water to form a gel, softening stool and slowing digestion gently. Insoluble fibre adds bulk and speeds transit — which sounds helpful for constipation but can actually worsen bloating and cramping in a sensitive gut.
| Fibre Type | Key Sources | Effect on Gut | Best For |
|---|---|---|---|
| Soluble | Oats, chia seeds, cooked carrots, zucchini, green beans | Softens stool, feeds microbiome, gentle on gut lining | Bloating, constipation, sensitive digestion |
| Insoluble | Raw salads, raw vegetables, bran, many seeds | Speeds transit, adds bulk | Healthy guts without significant sensitivity |
| Prebiotic (added) | Inulin, chicory root, FOS in packaged foods | Feeds specific bacteria but highly fermentable | Use with caution — can worsen gas and bloating |
| Whole food prebiotic | Garlic, leeks, onion, bananas, legumes | Feeds microbiome diversity | Tolerated better than isolated additives |
The practical takeaway: if bloating and constipation are prominent during perimenopause, increase soluble fibre sources gradually, stay well hydrated, and reduce raw, fibrous vegetables temporarily until the gut stabilises.
When should I see a doctor about digestive changes in perimenopause?
Any new or persistent digestive changes in your 40s deserve a conversation with your healthcare provider, even when perimenopause seems like the most obvious explanation. Thyroid dysfunction, medication side effects, and other gastrointestinal conditions can produce nearly identical symptoms and need to be ruled out.
Specific reasons to seek medical advice promptly include:
- Blood in stool or unexplained weight loss
- Bowel habit changes lasting more than a few weeks
- A family history of colorectal cancer (early screening may be appropriate from age 45)
- Symptoms that worsen significantly rather than fluctuating
Before starting new supplements or dramatically changing your diet, review your current medications with your doctor. Common midlife treatments — including iron, calcium, and certain antidepressants — can slow gut motility or irritate the gut lining, compounding perimenopause-related symptoms.
Getting a clear diagnosis is the foundation. Once other causes are excluded, you can focus confidently on evidence-based strategies for perimenopause and gut health.

The Bottom Line
- Perimenopause directly disrupts gut health through declining estrogen and progesterone, affecting the microbiome, gut motility, gut barrier integrity, and the gut-brain axis.
- The gut microbiome and hormones are mutually influential — a healthier microbiome supports better estrogen metabolism, which may ease hormonal symptoms.
- Bloating, constipation, and new food sensitivities in your 40s are often hormonal in origin, not isolated digestive problems — especially when other perimenopause signs are present.
- Diet, sleep, and stress management work together: no single change is enough on its own, but consistent daily habits create meaningful improvement.
- See your doctor first if symptoms are new, worsening, or accompanied by any red-flag signs — perimenopause is a likely cause, but it should be a diagnosis of inclusion, not assumption.
References: Bharwani et al. (2020); Kim & Kim (2021); Chen & Brar (2022); Peters BA et al., International Journal of Women's Health (2022); Zhao H et al., FEBS Letters (2019).
